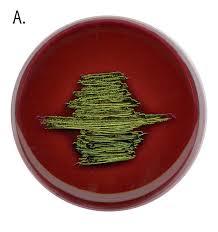
ईओसिन ब्लू

मर्क्साइड
Price:
नवीनतम कीमत पता करें
Minimum Order Quantity :
25 Kilograms
स्टॉक में
विस्तृत जानकारी
| भौतिक रूप | Powder |
| प्रॉडक्ट टाइप | Chemical Compound |
| कैस नं | 3051-09-0 |
| प्रॉपर्टीज़ | High purity, acts as a complexometric indicator, forms color complex with metals, changes color at endpoint. |
| एच एस कोड | 29339900 |
| सामग्रियां | Ammonium Purpurate |
| ईआईएनईसीएस नं | 221-336-6 |
| ग्रेड | Laboratory Grade |
| पवित्रता | 99% |
| दिखावट | Violet or pink crystalline powder |
| शेप | Crystalline, Crystalline |
| गंध | Odorless, Odorless |
| विषैला | Non-poisonous at standard lab concentrations, Non-poisonous at standard lab concentrations |
| आण्विक सूत्र | C8H8N6O6 |
| आणविक भार | 284.19 g/mol |
| मेल्टिंग पॉइंट | > 300°C (decomposes) |
| पीएच लेवल | Neutral to slightly acidic |
| अपवर्तक दर | Not determined |
| घुलनशीलता | Soluble in water |
| एप्लीकेशन | Complexometric titration indicator, especially for calcium and rare earth metals, Complexometric titration indicator, especially for calcium and rare earth metals |
| उपयोग | Analytical reagent in laboratories |
| स्टोरेज | Store in a cool, dry place, protected from light, Store in a cool, dry place, protected from light |
| शेल्फ लाइफ | 36 months (when properly stored) |
| स्ट्रक्चरल फॉर्मूला | Refer image |
| डिलीवरी का समय | 1हफ़्ता |
| डिलीवरी का समय | 1हफ़्ता |
| डिलीवरी का समय | 1हफ़्ता |
| डिलीवरी का समय | 1हफ़्ता |
| आपूर्ति की क्षमता | 100प्रति सप्ताह |
कंपनी का विवरण
व्यापार के प्रकार
निर्माता, निर्यातक, आपूर्तिकर्ता
कर्मचारी संख्या
10
स्थापना
2018
कार्य दिवस
से
जीएसटी सं
27AARCA1049D1ZS
भुगतान का प्रकार
अग्रिम नकद (सीआईडी)
इस विक्रेता से अधिक उत्पाद
विक्रेता विवरण
जीएसटी सं - 27AARCA1049D1ZS
नाम
हर्निश जूठनि
पता
२०२ २ण्ड फ्लोर मोदी हाउस बजाज क्रॉस रोड, कांदिवली (वेस्ट), मुंबई, महाराष्ट्र, 400067, भारत
गलत विवरण की रिपोर्ट करें